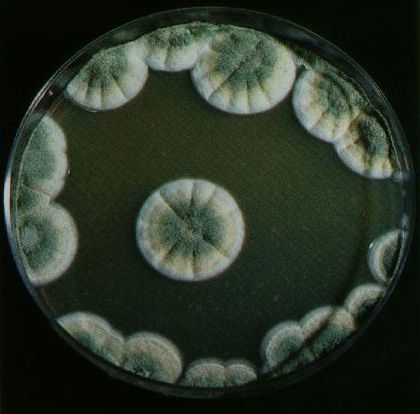

12. Les infections primaires
Par infections primaires, je parle de celle qui surviennent durant la phase sérile durant laquelle le mycélium envahit le milieu de culture ou la surface du agar.
Identification de l'infection
Y'a quelque chose qui cloche ! C'est sűrement ce que vous ętes en train de vous dire. Vous avez l'impression que quelque chose d'autre que du mycélium pousse dans votre boîte de Pétri ou votre bocal de seigle.
Un micro-organisme est entré d'une façon ou d'une autre dans le processus et est en train de prospérer ŕ la place du mycélium. Vous avez ŕ faire ŕ une contamination.
Les contamination prennent l'aspect de taches d'un peu toutes les couleurs (rouge, vert, noir,...) mais sauf le blanc. D'autre ressemblent ŕ un liquide visqueux blanchâtre et émet une odeur de moisi (infection bactérienne).
Cette infection bactérienne est moins facile ŕ détecter ŕ l'oeil nu lorsqu'elle apparaît dans un bocal de seigle, mais si vous constater que le mycélium s'arręte de pousser sans raison, il peut s'agir de cette infection : si aucune autre infection de couleur louche est présente, ouvrer le pot et sentir prudemment; si ça sent le moisi : jetez ou nettoyez ce pot. De toute façon, si vous ouvrez le pot avant que le mycélium n'ait colonisé la majeure partie du seigle, vous devrez le jeter, car l'infection devient inévitable.
Remarque importante :
Lorsque un pot de seigle colonisé par du mycélium saint est laissé en incubation pendant trop de temps, le mycélium commence ŕ arriver au bout de ses réserves de nourriture contenue dans le seigle, il commence ŕ secréter des déchets : ils prennent la forme de gouttes d'un liquide jaune et transparent. La présence de telles gouttes est sans danger mais doit ętre interprétée comme un signe indiquant qu'il est temps d'utiliser le bocal en mettant le seigle dans les conditions de fruitaisons.
En revanche sur les boîtes de Pétri, les infections sont facilement repérable, y compris les infections bactériennes. En général, les infections se développent plus vite que le mycélium: si de minuscules tâches apparaissent un jour, vous serez trčs vite fixé.
Voici ŕ quoi ressemble quelques infections les plus fréquentes.

A gauche : Penicillium (bleu) et Cladosporium (vert foncé).
A droite : Aspergillus : ! inhalation de spores dangereuse!
Mesures ŕ prendre
Il faut absolument empęcher que l'infection se répende : Evitez autant que possible d'ouvrir les récipient contaminé ŕ proximité des autres récipients non contaminé. Dans le cas oů on veut garder le récipient pour observation ou pour une tentative d'épuration, il ne faut pas les stocker avec les récipients sains.
Evidemment, il faut se laver parfaitement les mains apčs avoir manipulé des récipients infectés.
Lorsque je constate la contamianation d'une boîte de Pétri, je prend les mesures qui suivent :
- Si j'estime qu'elle est utilisable dans le but d'épuration (découpe d'une partie de mycélium apparemment non contaminée), je la stocke et je l'utilise le plus vite possible.
- Sinon je la met dans un sac plastique et je la jette tout de suite.
Dans le cas d'une contamination d'un bocal de seigle :
- Je visse couvercle du bocal et l'emmčne dans un autre endroit que le lieu d'incubation
- J'enlčve le couvercle et recouvre l'ouverture d'un petit sac plastique. Je renverse le tout et tapotte le pot pour que tout le seigle tombe. Je ferme bien le plastique et le jette. Je met un peu d'eau de Javel dans le bocal et le referme bien. Je le secoue pour bien répartir le désinfectant. Le lendemain je le lave.
Implication sur votre santé
Il faut garder ŕ l'esprit que l'inhalation de spores de certaines organismes peuvent ętre trčs dangereux; comme c'est le cas pour le aspergillus.
Voici donc quelques rčgles ŕ respecter :
- Lorsque l'infection est facilement identifiable (c.a.d. qu'il ne s'agit pas d'une infection bactérienne), ne pas s'aventurer ŕ sentir ou toucher les parties contaminées.
- Si vous "devez" tout de męme sentir une culture suspecte, veiller ŕ ne pas respirer pleinement, prudence ...
Comment identifier la source de l'infection
Voici les vecteurs les plus féquents (du plus au moins) :
- Le cultivateur (oui,oui, je parle de vous). Ses mains, ses habits, ses expirations, ...
- L'air
- Le milieu de culture
A vous d'analyser quelle pourrait ętre la source de contamination.
Si vous constatez que tous vos récipiens sont contaminés, voici un bon truc :
Prenez soins de toujours laisser un bocal/Pétri non-innoculé. Ainsi si tout vos récipients innoculés sont contaminés mais pas les récipients témoins, la contamination a eu lieu lors de l'innoculation. Si les récipients tests sont aussi contaminés, l'infection a eu lieu avant l'innoculation et peut ętre due ŕ une mauvaise stérilisation ou des mauvaises manipulations lors de la préparation du agar des boîtes de Pétri.
Rassurez-vous, si vous avez appliqué toutes les consignes de ce documents, vous ne devriez presque pas avoir de problčmes.